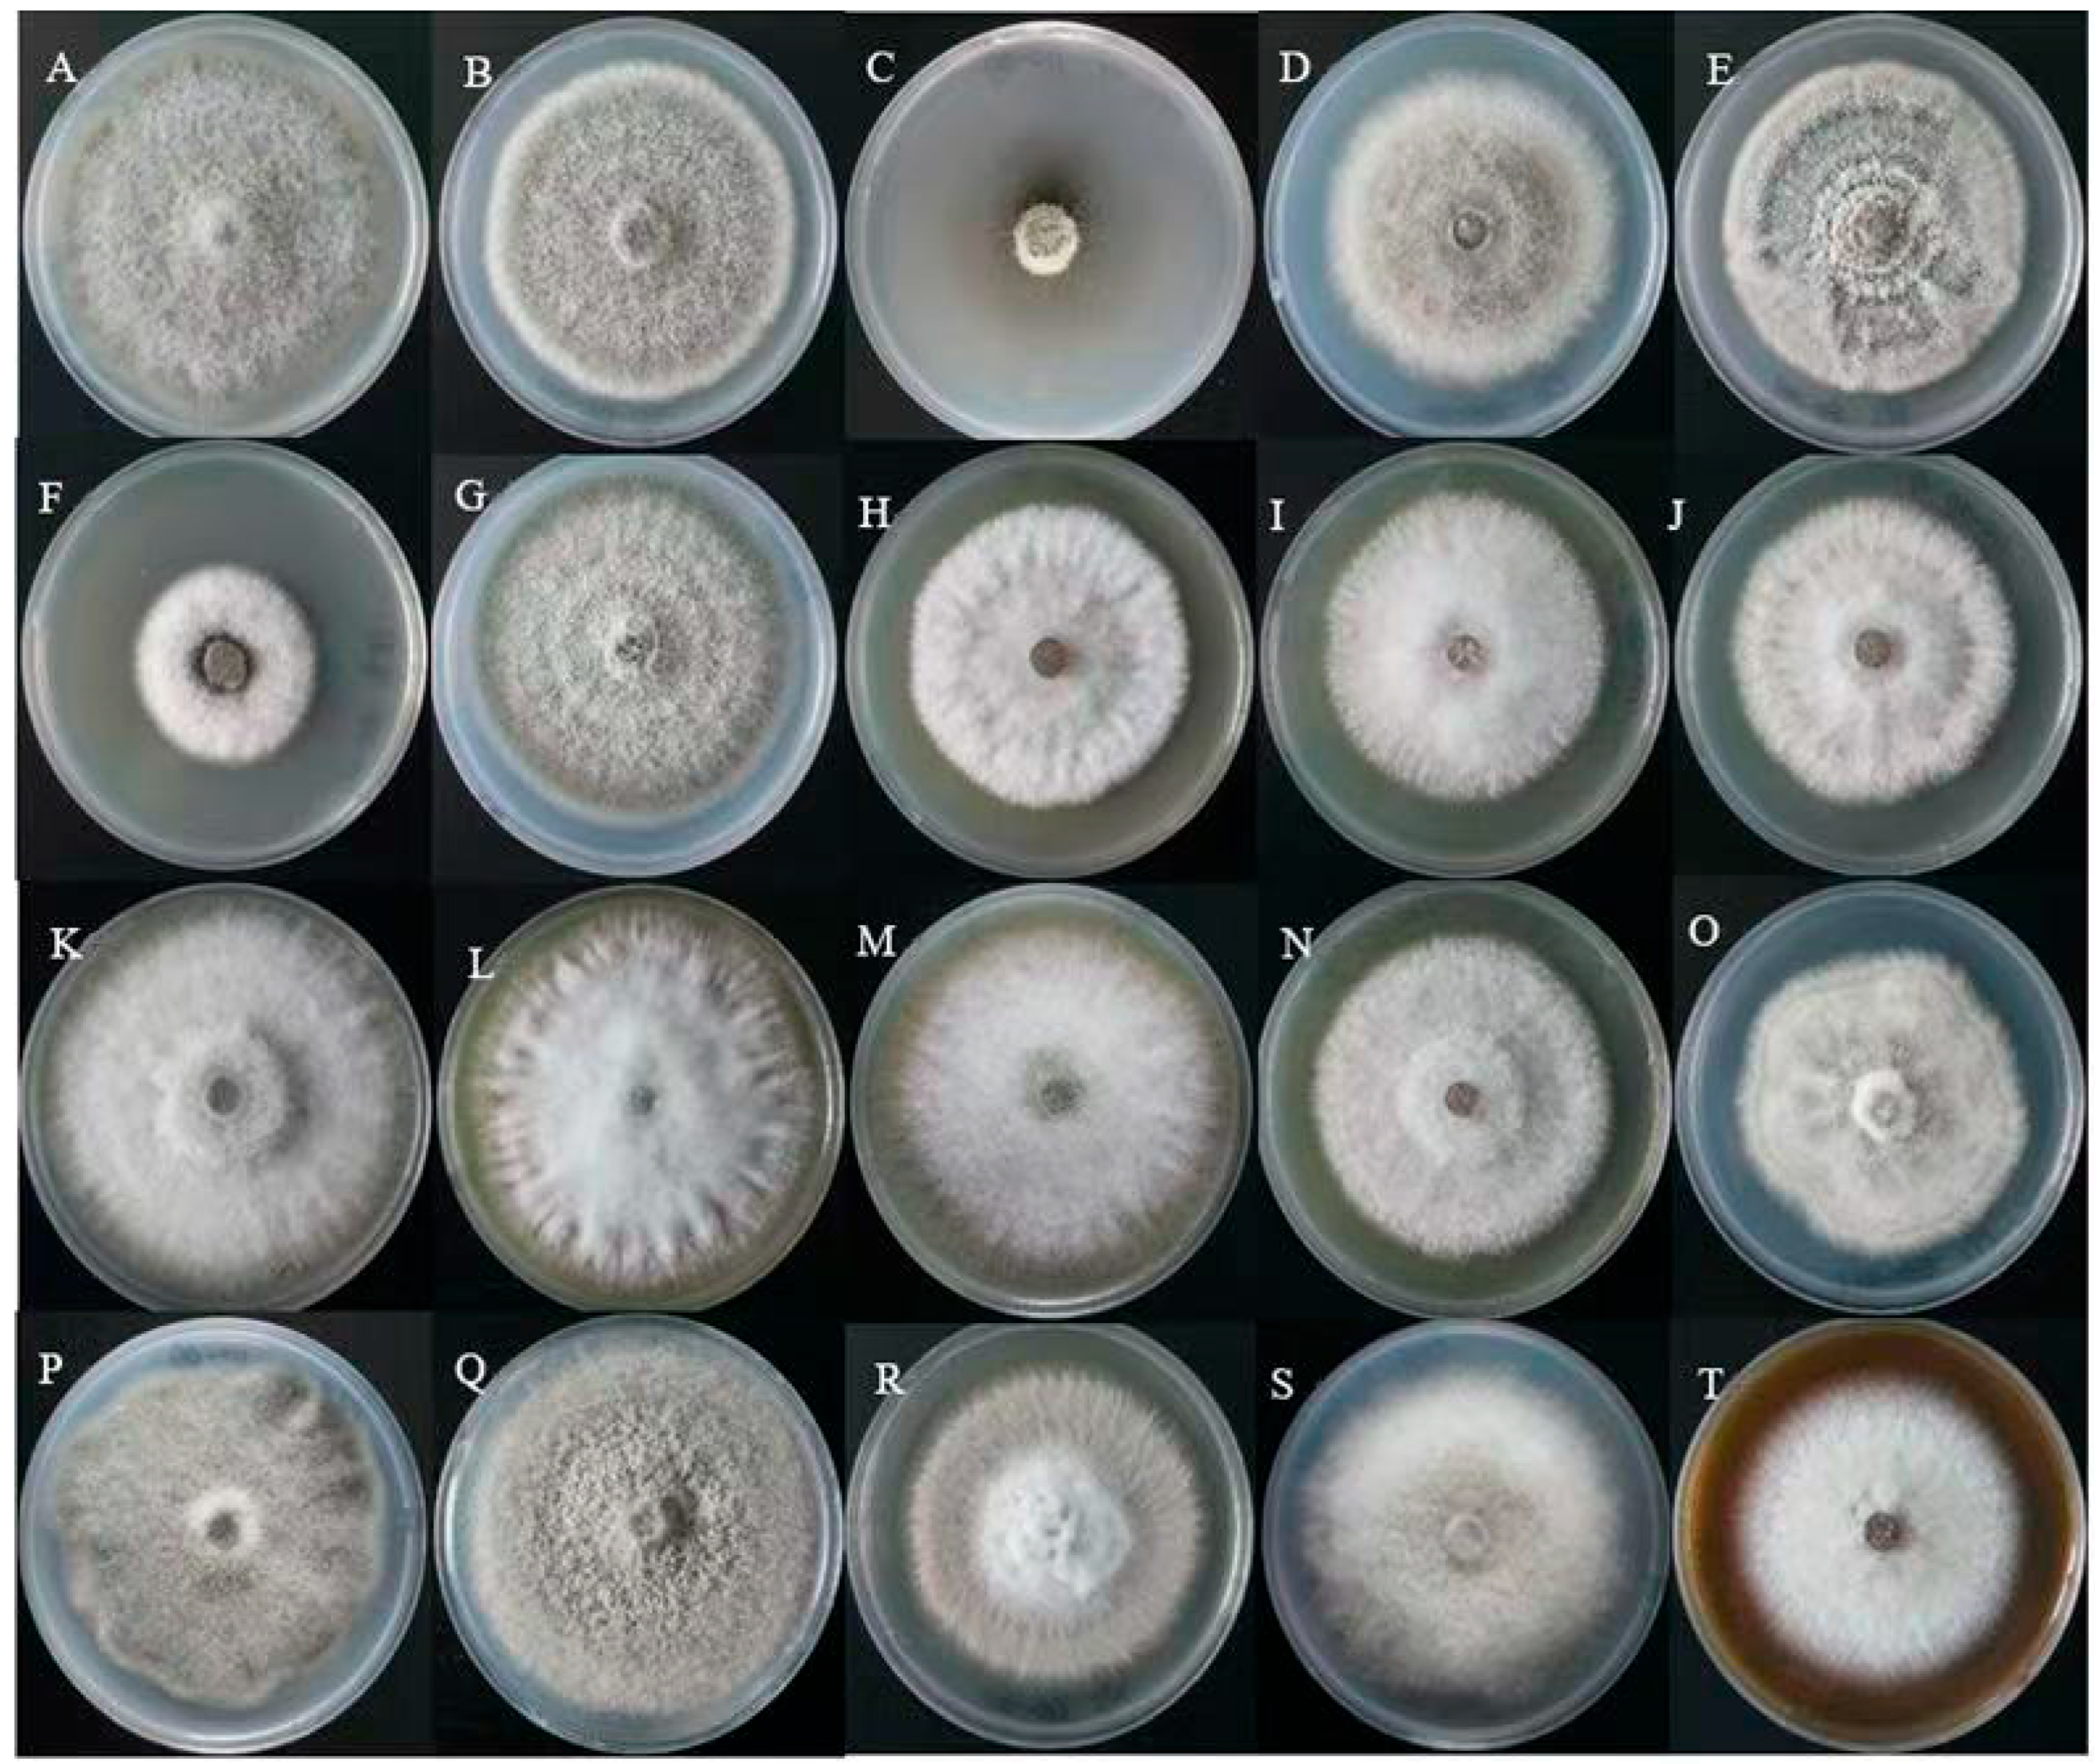
Fermentation 11 00582 g002 Fermentation 11 00582 g002

Preparation and Herbicidal Activity of a Microbial Agent Derived from Alternaria gaisen Strain GD-011
Abstract
1. Introduction
2. Materials and Methods
2.1. Field Sampling, Microbial Isolation and Spore Inoculum Preparation
2.2. Optimization of Solid-State Fermentation Substrates Through Single-Factor Experiments and Orthogonal Array Design
2.3. Screening of Carriers and Additives
2.4. Preliminary Preparation of Wettable Powders
2.5. Valuation of Herbicidal Activity of GD-011 Microbial Inoculant Against Weeds in Pot Experiments
2.6. Statistical Analyses
3. Results
3.1. Results of the One-Factor Screening and Orthogonal Combination Optimization of the Solid State Fermentation Substrates
3.2. Screening of GD-011 Strain Carriers and Auxiliaries
3.3. Preliminary Preparation of Wettable Powders
3.4. Determination of the Pathogenicity of Wettable Powders on Potted Weeds
4. Discussion
5. Conclusions
Author Contributions
Funding
Institutional Review Board Statement
Informed Consent Statement
Data Availability Statement
Conflicts of Interest
References
- Song, W. Weed Community Composition and Control Strategies in Oat Fields of Qinghai. Master’s Thesis, Qinghai University, Xining, China, 2021. [Google Scholar] [CrossRef]
- Suo, D.; Zhang, R.; Tong, L. Reflections on Ecological Protection and High-Quality Development in the Source Region of the Yellow River. Qinghai Soc. Sci. 2022, 5, 43–52. [Google Scholar] [CrossRef]
- Huang, Y.; Wu, D.; Huang, Z.; Li, X.; Merotto, A.; Bai, L.; Fan, L. Weed genomics yielding insights into the genetics of weedy traits for crop improvement. aBIOTECH 2023, 4, 20–30. [Google Scholar] [CrossRef]
- Villalobos, F.J.; Mateos, L.; Fereres, E. Control of Weeds and Other Biotic Factors; Springer: Cham, Switzerland, 2024. [Google Scholar]
- Chen, S.; Qiang, S. Current status and future trends in the research and development of bioherbicides. Chin. J. Biol. Control. 2015, 31, 770–779. [Google Scholar] [CrossRef]
- Kumar, M.; Dash, S.; Mahlknecht, J.; Kolok, A.; Dogra, S.; Kuroda, K.; Tobino, T.; Mora, A.; Kazmi, A.A.; Singh, R.; et al. Understanding the pathways, pollution and potential solutions pertaining to pesticides: Circular engineering for persistent chemicals. Curr. Opin. Environ. Sci. Health 2025, 46, 100638. [Google Scholar] [CrossRef]
- Song, Y. Development of Wettable Powder Formulation of Streptomyces for Biological Control of Potato Common Scab. Master’s Thesis, Inner Mongolia Agricultural University, Hohhot, China, 2022. [Google Scholar] [CrossRef]
- Luo, Z.; Ma, S.; Zhang, Y.; Li, H.; Yuan, Y. A pesticide powder prepared from four Chinese herbal medicine extracts as the active ingredient: Optimization of preparation process and quality examination. J. Nat. Pestic. Res. 2025, 11, 100109. [Google Scholar] [CrossRef]
- Wen, J.; Pi, N.; He, F.; Zeng, Y.; Weng, Q.; Luo, J. Optimization of the Fermentation and Preparation of the Wettable Powder Formulation of Bacillus velezensis F0b. Microorganisms 2025, 13, 560. [Google Scholar] [CrossRef] [PubMed]
- Liu, S.; Cao, Y. Application Status and Development Prospects of Microbial-derived Pesticides. J. Henan Agric. Sci. 2015, 44, 22–25+30. [Google Scholar] [CrossRef]
- Zhang, S.; Zhu, H.; Cheng, L.; Cheng, H. Optimization of Fermentation Conditions for Alternaria alternata GD-011 in Pear. J. Anhui Agric. Sci. 2025, 1–5. [Google Scholar]
- He, Y.; Zhu, H. Preliminary Study on the Herbicidal Mechanism of Alternaria alternata GD-011 Strain in Pear. Acta Agric. Zhejiangensis 2024, 36, 1094–1101. [Google Scholar]
- Zhu, H.; Ma, Y.; Guo, Q. Solid-state fermentation conditions of Fusarium proliferatum GD-5 and its herbicidal activity against Chenopodium album and Elsholtzia densa. J. Plant Prot. 2018, 45, 1154–1160. [Google Scholar]
- Zhu, H.; Ma, Y.; Guo, Q. Preliminary Development of HZ-31 Trichoderma polysporum Agent and Its Virulence Effect on Broadleaf Weeds. Southwest China J. Agric. Sci. 2017, 30, 606–609. [Google Scholar] [CrossRef]
- He, Q. Potential Evaluation and Host Range Testing of Bio-Control Fungi for Microstegium vimineum. Master’s Thesis, Nanjing Agricultural University, Nanjing, China, 2017. [Google Scholar] [CrossRef]
- Zhu, W.; Liu, Y.; Zhao, C.; Wang, J. Overview and progress of microbial pesticides in China. Ind. Microbiol. 2024, 54, 153–155. [Google Scholar]
- Luan, H.; Zhang, Y.; Qiu, W.; Zhang, X.; Liu, M.; Feng, W.; Xu, W.; Wang, F.; Xuan, H.; Song, P. Research progress on microbial pesticides. Pestic. Biochem. Physiol. 2025, 213, 106512. [Google Scholar] [CrossRef]
- Zhuang, X.; Cheng, L.; Guo, Q. Development of Fusarium avenaceum GD-2 wettable powder and its control efficacy against wild oats. J. Qinghai Univ. 2020, 38, 9–17+43. [Google Scholar] [CrossRef]
- Chen, S.; Yin, C.; Qiang, S.; Zhou, F.; Dai, X. Chloroplastic oxidative burst induced by tenuazonic acid, a natural photosynthesis inhibitor, triggers cell necrosis in Eupatorium adenophorum Spreng. Biochim. Biophys. Acta 2010, 1797, 391–405. [Google Scholar] [CrossRef] [PubMed]
- Duke, S.O. Herbicide and Pharmaceutical Relationships. Weed Sci. 2010, 58, 334–339. [Google Scholar] [CrossRef]
- Li, H.; Zhang, P.; Tang, C.; Yang, S.; Cao, R. Preliminary exploration of fed-batch fermentation conditions for taxol production by Aspergillus fumigatus TMS-26. Mycosystema 2018, 37, 502–510. [Google Scholar] [CrossRef]
- He, Q.; Li, B.; Wang, D.; Wu, H. Nematicidal activity and fermentation optimization of Aspergillus japonicus ZW1 fermentation broth. Chin. J. Biol. Control. 2020, 36, 619–627. [Google Scholar] [CrossRef]
- Mamatha, S.S.; Ravi, R.; Venkateswaran, G. Medium Optimization of Gamma Linolenic Acid Production in Mucor rouxii CFR-G15 using RSM. Food Bioprocess Technol. 2008, 1, 405–409. [Google Scholar] [CrossRef]
- Liu, J.H.; Chen, Y.T.; Li, H.; Jia, Y.P.; Xu, R.D.; Wang, J. Optimization of fermentation conditions for biosurfactant production by Bacillus subtilis strains CCTCC M201162 from oilfield wastewater. Environ. Prog. Sustain. Energy 2015, 34, 548–554. [Google Scholar] [CrossRef]
- Miao, L.; Zhang, P.; Zhou, P.; Yu, L. Optimization of fermentation conditions for taxol-producing endophytic fungus Cladosporium cladosporioides MD2. Microbiol. China 2013, 40, 1033–1040. [Google Scholar] [CrossRef]
- Lin, Z.; Zhu, H. Screening of fermentation medium and optimization of conditions for herbicidal strain HZ-011. J. South. Agric. 2021, 52, 1931–1941. [Google Scholar]
- Zhu, H.; Ma, Y.; Wei, Y.; Guo, Q. Fermentation conditions of Trichoderma polysporum HZ-31 strain. Acta Agric. Boreali-Occident. Sin. 2017, 26, 132–136. [Google Scholar]
- Jiang, D.; Guo, X.; Ma, J.; Wang, X.; Yang, S. Response surface optimization of medium formulation and fermentation conditions for Aspergillus sclerotiorum As-68 strain antagonistic against Xanthomonas oryzae pv. oryzae. J. Zhejiang Norm. Univ. 2021, 44, 188–196. Available online: https://doi.org/10.16218/j.issn.1001-5051.2021.02.010. [CrossRef]
- Yang, Y.; Zhuang, X.; Cheng, L.; Guo, Q. Optimization of fermentation medium and conditions for Aureobasidium pullulans PA-2. J. South. Agric. 2019, 50, 1998–2008. [Google Scholar]
- Yin, Y.; Wu, J.; Tan, J.; Hao, D. Optimization of fermentation medium and conditions for pine endophytic Bacillus cereus NJSZ-13 strain. J. Zhejiang For. Sci. Technol. 2020, 40, 9–17. [Google Scholar]
- Wan, Q.; Xiong, W.; Zhang, J.; Deng, Q. Identification of a wild Lepista sordida strain and its medium screening. Edible Fungi China 2025, 44, 1–6. [Google Scholar]
- Duré, L.M.M.; Mascarin, G.M.; Bettiol, W. Optimization of endospore production by solid and liquid fermentation for the development of effective formulations of Bacillus velezensis-based products. Braz. J. Microbiol. 2025, 56, 1253–1261. [Google Scholar] [CrossRef]
- Chen, W.; Feng, H.; Ou, J.; Zhang, S.; Meng, P. Screening and optimization of carbon and nitrogen sources in liquid medium for Armillaria mellea. J. Northwest AF Univ. 2020, 48, 128–136. [Google Scholar] [CrossRef]
- Cheng, H.; Cheng, L.; Zhu, H.; Li, J.; Wei, Y. Herbicidal activity of Alternaria alternata DT-DYLC strain and its safety to crops. Chin. J. Biol. Control. 2023, 39, 418–428. [Google Scholar] [CrossRef]

| 4-Factor Quality(g) | ||||
|---|---|---|---|---|
| Recipe Number | Wheat Straw Chaff | Wheat Bran | Rapeseed Cake | Corn Flour |
| 1 | 24.5 | 16.5 | 0.8 | 8.2 |
| 2 | 18.3 | 18.3 | 1.2 | 12.2 |
| 3 | 14.5 | 19.4 | 1.5 | 14.6 |
| 4 | 21.7 | 10.9 | 1.1 | 16.3 |
| 5 | 24.1 | 18.1 | 1.8 | 6 |
| 6 | 19.8 | 19.8 | 0.5 | 9.9 |
| 7 | 26.8 | 10.8 | 1.6 | 10.8 |
| 8 | 22.3 | 13.4 | 0.9 | 13.4 |
| 9 | 24.7 | 19.8 | 0.5 | 5 |
| Strain GD-011 | |||
|---|---|---|---|
| Substrate | OD Value | Spore Production × 1010 (Spores/mL) | |
| Straw bran | 0.47 ± 0.04c | 0.69 ± 0.07c | |
| Wheat bran | 0.79 ± 0.02a | 1.14 ± 0.10a | |
| Maize flour | 0.70 ± 0.02b | 0.87 ± 0.03b | |
| Rapeseed cake | 0.21 ± 0.02d | 0.43 ± 0.05d | |
| Sheep manure | 0.40 ± 0.02c | 0.33 ± 0.04d | |
| Strain GD-011 | |||
|---|---|---|---|
| Combination | OD Value | Spore Production × 1010 (Spores/mL) | |
| 1 | 0.43 ± 0.12d | 1.12 ± 0.17d | |
| 2 | 0.85 ± 0.28b | 0.92 ± 0.12d | |
| 3 | 1.10 ± 0.32a | 4.8 ± 0.39a | |
| 4 | 0.85 ± 0.03b | 1.92 ± 0.24c | |
| 5 | 0.61 ± 0.03c | 3.01 ± 0.19b | |
| 6 | 0.51 ± 0.14d | 3.37 ± 0.39b | |
| 7 | 0.60 ± 0.20c | 1.28 ± 0.20cd | |
| 8 | 0.84 ± 0.23b | 3.12 ± 0.26b | |
| 9 | 0.74 ± 0.01bc | 3.49 ± 0.25b | |
| Carrier or Auxiliary | Colony Diameter | OD600 Value | |
|---|---|---|---|
| 3d | 6d | ||
| Potato Dextrose Agar medium | 3.83 ± 0.17 b | 7.13 ± 0.09 ab | 0.22 ± 0.01 c |
| Diatomaceous earth | 4.10 ± 0.16 ab | 7.53 ± 0.21 a | 0.41 ± 0.13 a |
| Nekal | 0 ± 0 d | 0 ± 0 e | 0 ± 0 d |
| Limestone | 4.03 ± 0.13 a | 6.97 ± 0.13 ab | 0.25 ± 0.09 c |
| Ball clay | 3.73 ± 0.21 b | 7.14 ± 0.17 ab | 0.20 ± 0.06 c |
| Sodium dodecyl sulfate | 1.27 ± 0.09 c | 1.73 ± 0.13 d | 0.28 ± 0.03 c |
| Humic acid | 4.27 ± 0.13 a | 7.13 ± 0.13 ab | 0.33 ± 0.0 b |
| Dextrin | 3.43 ± 0.21 bc | 6.77 ± 0.21 ab | 0.30 ± 0.03 b |
| Algin | 3.57 ± 0.05 bc | 6.27 ± 0.38 b | 0.32 ± 0.04 b |
| Amylogen | 4.17 ± 0.13 ab | 6.07 ± 0.25 b | 0.28 ± 0.01 c |
| Bentonite | 3.80 ± 0.22 b | 7.67 ± 0.60 a | 0.37 ± 0.18 b |
| Light calcium carbonate | 3.83 ± 0.13 b | 7.47 ± 0.42 a | 0.30 ± 0.02 b |
| Carbon-white | 3.97 ± 0.05 b | 7.03 ± 0.17 ab | 0.35 ± 0.05 b |
| Heavy calcium carbonate | 3.96 ± 0.05 ab | 6.83 ± 0.13 ab | 0.26 ± 0.03 c |
| Carboxymethylcellulose | 3.43 ± 0.17 bc | 6.47 ± 0.17 b | 0.26 ± 0.07 c |
| Carboxymethylcellulose sodium | 3.70 ± 0.08 b | 7.13 ± 0.34 ab | 0.28 ± 0.04 c |
| Kaolinite | 4.47 ± 0.05 a | 7.47 ± 0.09 a | 0.29 ± 0.05 c |
| Poval | 3.60 ± 0.23 b | 5.80 ± 0.16 c | 0.45 ± 0.14 a |
| Sodium lignin sulfonate | 3.63 ± 0.13 b | 7.30 ± 0.14 a | 0.32 ± 0.07 b |
| Weed Name | Incidence of Disease (%) | Control Effect of Fresh Weight (%) |
|---|---|---|
| C. album | 80.83 ± 5.14 a | 79.87 ± 0.87 a |
| E. densa | 65.66 ± 4.16 b | 61.39 ± 3.69 c |
| G. aparine | 78.38 ± 4.45 ab | 74.64 ± 4.39 b |
Disclaimer/Publisher’s Note: The statements, opinions and data contained in all publications are solely those of the individual author(s) and contributor(s) and not of MDPI and/or the editor(s). MDPI and/or the editor(s) disclaim responsibility for any injury to people or property resulting from any ideas, methods, instructions or products referred to in the content. |
© 2025 by the authors. Licensee MDPI, Basel, Switzerland. This article is an open access article distributed under the terms and conditions of the Creative Commons Attribution (CC BY) license (https://creativecommons.org/licenses/by/4.0/).
Share and Cite
Zhang, S.; Zhu, H.; Li, H.; Ma, Y. Preparation and Herbicidal Activity of a Microbial Agent Derived from Alternaria gaisen Strain GD-011. Fermentation 2025, 11, 582. https://doi.org/10.3390/fermentation11100582
Zhang S, Zhu H, Li H, Ma Y. Preparation and Herbicidal Activity of a Microbial Agent Derived from Alternaria gaisen Strain GD-011. Fermentation. 2025; 11(10):582. https://doi.org/10.3390/fermentation11100582
Chicago/Turabian StyleZhang, Suifang, Haixia Zhu, Huan Li, and Yongqiang Ma. 2025. "Preparation and Herbicidal Activity of a Microbial Agent Derived from Alternaria gaisen Strain GD-011" Fermentation 11, no. 10: 582. https://doi.org/10.3390/fermentation11100582
APA StyleZhang, S., Zhu, H., Li, H., & Ma, Y. (2025). Preparation and Herbicidal Activity of a Microbial Agent Derived from Alternaria gaisen Strain GD-011. Fermentation, 11(10), 582. https://doi.org/10.3390/fermentation11100582

